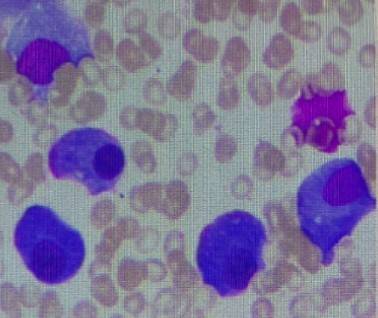
4.jpg

多发性骨髓瘤(MM)作为一种由浆细胞异常增殖所致的血液系统恶性肿瘤,目前仍无法实现根治,其治疗理念已逐步从追求短期缓解转向以深度、持久疾病控制为核心的全程慢病管理。对于新诊断多发性骨髓瘤(NDMM)患者,尤其是伴有遗传学异常、年龄较大或存在基础疾病的复杂病例,在通过强化诱导治疗最大限度地降低肿瘤负荷后,如何选择安全、有效且便捷的持续治疗方案,已成为巩固疗效、延缓疾病进展及改善患者远期预后的关键。达雷妥尤单抗(Dara)作为一种靶向CD38的单克隆抗体,可通过多种机制发挥抗骨髓瘤效应,是诱导治疗阶段的重要选择;伊沙佐米(I)作为新一代口服蛋白酶体抑制剂,具有神经毒性低、对肾功能影响小以及口服给药便利等特点,为MM的长期持续治疗提供了理想的药物选择。
基于上述背景,为进一步验证“达雷妥尤单抗诱导序贯伊沙佐米持续治疗”策略在真实世界临床实践中的价值,【肿瘤资讯】特邀浙江大学医学院附属第一医院孟海涛教授与浙江大学医学院附属第二医院肖希斌教授,结合三例具有不同临床特征的NDMM患者的诊疗过程,深入剖析该治疗策略在真实世界中的应用价值,以期为临床个体化治疗提供参考。
病例一
患者概况
患者男性,73岁,2025年4月因“发现左胸锁关节体表肿块1年余”就诊。患者无明显诱因出现局部肿块,无伴发疼痛、肢体活动障碍等不适,病程中未予特殊干预,为求进一步诊治入院。
检查结果
血常规:白细胞 4.8×10⁹/L,中性粒细胞绝对值 2.95×10⁹/L,血红蛋白 82g/L,血小板 196×10⁹/L。
生化:白蛋白 28.4g/L,β2微球蛋白 6.06mg/L,钙 1.99mmol/L,乳酸脱氢酶 140U/L,免疫球蛋白G 51.4g/L,CRP 5.5mg/L。
血清免疫固定电泳:IgG(+),λ(+)。
血清游离轻链定量:λ轻链 1188.68mg/L,κ轻链 16.1mg/L,κ/λ比值 0.0135。
骨髓细胞学检查:异常浆细胞比例19%。
骨髓流式细胞术:浆细胞占有核细胞总数约5.9%,免疫表型为CD45⁻,CD38⁺⁺,CD138⁺⁺,CD56⁺⁺,CD19⁻,CD20⁻,伴胞内免疫球蛋白λ轻链限制性表达,提示为单克隆浆细胞。
骨髓活检病理:骨髓穿刺组织内见多量浆细胞,免疫组化显示伴轻链限制性表达,符合浆细胞瘤,免疫组化:CD3(散在+),CD20(散在+),CD79a(散在+),CD38(较多浆细胞+),CD138(较多浆细胞+),Kappa(-),Lambda(+),CD56(+),CD19(-),MUM1(-),CD117(-),BCMA(+),Ki-67(2%+)。

左胸锁关节体表肿块病理:恶性肿瘤,结合免疫组化考虑浆细胞骨髓瘤,免疫组化:CK-PAN(-),Vimentin(+),CD45(LCA)(-),CD3(-),CD20(-),CD79a(-),S100(-),CD30(-),ALK(-),HMB45(-),CD38(+),Desmin(-),CAM5.2(-),CD138(+),Kappa(-),Lambda(+),BCMA(+),GATA3(-),p63(-),Ki-67(30%)。

PET-CT:1. 各处多发骨骼骨质破坏,部分伴软组织肿块形成,糖代谢明显增高,纵隔(2L区)、胸骨左旁、左腋下多发淋巴结肿大伴糖代谢明显增高,考虑为多发性骨髓瘤病变;2. 双侧颈部(Ⅰb、Ⅱ区)、余纵膈、两侧肺门淋巴结糖代谢增高,考虑为淋巴结炎;3. 两侧基底节区腔隙灶;两肺肺气肿伴肺大泡形成,两肺散在纤维增殖灶;前列腺增生伴钙化。
诊断
1. 多发性骨髓瘤(IgG λ型,DS IIIA期,ISS III期)。
治疗经过
2025年4月~2025年6月:予DRD方案(达雷妥尤单抗+来那度胺+地塞米松)治疗2个疗程,患者病情稳定,疗效评估达非常好的部分缓解(VGPR)。
2025年7月~2025年12月:调整为IRd方案(伊沙佐米+来那度胺+地塞米松)治疗6个疗程,疗效评估达完全缓解(CR)。
疗效与转归
接受DRD方案诱导治疗后,患者的血清M蛋白含量4.57g/L,血清免疫固定电泳IgG(+)、λ(+),血清游离轻链λ 13.57mg/L、κ 10.11mg/L,κ/λ 0.745,疗效评估为VGPR。转换为IRd方案治疗后,患者的血清免疫固定电泳IgG(-)、κ(-),骨髓活检免疫组化检测克隆性浆细胞阴性,血清游离轻链比例正常,MRD检测-,疗效提升至CR。治疗期间患者未出现明显药物相关不良反应,耐受性良好,可正常完成门诊随访及用药。
病例小结
该例为老年NDMM患者,肿瘤负荷较高,经达雷妥尤单抗为基础的诱导方案治疗快速实现VGPR后,及时转换为伊沙佐米为基础的全口服方案,进一步深化缓解至CR。口服方案大幅提升了老年患者的治疗便利性与依从性,无需反复住院给药,充分体现了“Dara诱导序贯I持续治疗”策略在老年MM患者序贯治疗中的可行性与临床有效性。
病例二
患者概况
患者女性,71岁,2021年1月因“腰痛1月”就诊,外院腰椎磁共振示腰1、3、5椎体异常信号,考虑转移瘤或血液系统肿瘤可能,为进一步诊治收住入院。
检查结果
血常规:白细胞 6.0×10⁹/L,中性粒细胞绝对值 3.72×10⁹/L,血红蛋白 99g/L,血小板 235×10⁹/L。
生化:白蛋白 34.4g/L,β2微球蛋白 5.41mg/L,钙 2.30mmol/L。
血清免疫球蛋白+补体:免疫球蛋白G 51.30g/L,免疫球蛋白A<0.28g/L,免疫球蛋白M<0.19g/L。
血清蛋白电泳:血清M蛋白 34.05g/L。
尿蛋白电泳:尿M蛋白 658.20mg/24h。
血清免疫固定电泳:IgG/κ型M蛋白(+)。

血清游离轻链定量:κ轻链 1566mg/L,λ轻链 15.04mg/L,κ/λ比值 104。
骨髓细胞学检查:浆细胞占38%,以幼稚性细胞为主。
骨髓流式细胞术:37.3%单克隆浆细胞(CD38+,CD138+,CD56+,CD20-),伴胞内免疫球蛋白κ轻链限制性表达。
FISH:p53(17p13.1)基因缺失。
诊断
1. 多发性骨髓瘤(IgG/κ型,DS III期,ISS II期,高危)。
治疗经过
2021年1月~2021年5月:予DRD方案(达雷妥尤单抗+来那度胺+地塞米松)治疗4个疗程,2疗程后疗效评估达PR,4疗程后疗效评估达CR。
2021年5月至今:予IRd方案(伊沙佐米+来那度胺+地塞米松)序贯维持治疗,2疗程后疗效评估达到严格意义上的完全缓解(sCR),持续治疗至今。
疗效与转归
DRD方案治疗2个疗程后,患者免疫球蛋白IgG降至正常,疗效评估为PR;4个疗程后免疫固定电泳转阴,疗效达到CR。IRd方案维持治疗2个疗程后,患者骨髓活检免疫组化检测克隆性浆细胞阴性,血清游离轻链比例正常,疗效提升至sCR。长期随访至2025年6月,患者已接受IRd方案维持治疗约50个月,血尿免疫固定电泳持续阴性,血尿游离轻链比值保持正常,实现超50个月的持续深度缓解;整个治疗过程中患者耐受性良好,未出现药物相关不良反应,生活质量未受明显影响。

病例小结
该例为合并p53基因缺失的高危初治MM患者,经达雷妥尤单抗为基础的诱导方案治疗4个月后,实现从疾病活动期到CR的跨越;后续序贯伊沙佐米为基础的全口服方案维持治疗,不仅维持了缓解状态,更将缓解深度提升至sCR,且持续缓解时间长达50个月,治疗期间安全性良好。该病例证实了“Dara诱导序贯I持续治疗”策略在高危MM患者长期疾病管理中的核心价值与显著获益。
病例三
患者概况
患者女性,70岁,2023年12月因“双侧臀部疼痛7月余”就诊。患者既往有高血压、糖尿病、心脏病病史,ECOG评分2分,病程中臀部疼痛呈持续性,活动后加重,影响日常活动,外院骨盆MRI提示恶性肿瘤可能,为进一步诊治入院。
检查结果
血常规:血红蛋白 130g/L,余两系正常。
生化:白蛋白 30.5g/L,球蛋白 58.4g/L,白球比倒置,β2微球蛋白 3.58mg/L,肌酐、电解质、乳酸脱氢酶均正常。
血清免疫固定电泳:IgG-λ型M蛋白。
骨盆MRI:骨盆诸骨多发异常强化信号影伴右侧髂骨软组织信号,考虑恶性肿瘤。

PET-CT:右侧髂骨明显骨质破坏伴软组织形成,放射性摄取异常增高(SUVmax=21.20),全身多骨(颅骨、脊柱、肋骨、锁骨、肩胛骨、四肢骨近端等)可见多发放射性摄取增高灶(SUVmax=11.62),提示多发性溶骨性病变。
骨髓细胞学检查:浆细胞比例25.5%,骨髓流式证实单克隆浆细胞来源,异常细胞约占有核细胞的5.8%,表达CD27、CD38、CD56、CD117、CD138、cLambda,不表达CD19、CD28,考虑为异常单克隆的浆细胞。
骨髓活检病理:浆细胞骨髓瘤。免疫组化结果:CD79a(+),CD20(-),CD38(++),CD138(++),Kappa(-),Lambda(+++),EMA(-),CD3(散在小T细胞+),CD99(-),Fli-1(-),Syn(-),CgA(-),CD56(++),S-100(-),Ki-67约30%。
FISH:1q21扩增和13q缺失(涉及RB1/D13S319位点)。
诊断
1. 多发性骨髓瘤(IgG-λ型,ISS II期,R-ISS II期,高危)。
治疗经过
2023年12月~2024年3月:予DVD方案(达雷妥尤单抗+硼替佐米+地塞米松)诱导治疗4个疗程,疗效评估达VGPR。
2024年4月~2024年11月:调整为IR方案(伊沙佐米+来那度胺)维持治疗8个疗程,疗效评估达CR。
2024年12月至今:予伊沙佐米单药口服维持治疗,持续保持深度缓解状态。
疗效与转归
DVD方案诱导治疗后,患者血清IgG降至11.6g/L,24h尿轻链定量<100mg,骨髓浆细胞比例降至0.5%,原右侧髂骨软组织病灶SPD缩小超过90%,疗效评估为VGPR。IR方案维持治疗后疗效提升至CR,转换为伊沙佐米单药维持治疗期间,患者固相电泳显示M蛋白转阴,血清IgG稳定在11.6g/L,24h尿轻链定量持续<100mg,骨髓浆细胞比例维持0.5%且骨髓MRD阴性。影像学检查示无新发骨损伤病灶,原右侧髂骨软组织病灶持续缩小且PET-CT显示代谢活性消失。安全性评估显示,整个治疗过程中患者耐受性良好,未发生严重感染,未出现周围神经病变(PN),仅出现轻度骨髓抑制,不良事件(AE)等级<2级。
病例小结
该例为合并高血压、糖尿病、心脏病等基础疾病的高危NDMM患者,伴1q21扩增和13q缺失双重遗传学异常,且体能状态一般。经达雷妥尤单抗为基础的诱导方案治疗后,采用“从IR联合方案向伊沙佐米单药维持转换”的阶梯式“Dara诱导序贯I持续治疗”策略,实现了从VGPR到CR且MRD阴性的持续深度缓解。全口服方案有效规避了注射制剂的相关不良反应,适配基础疾病患者的长期治疗需求,同时显著提升治疗依从性,为高危合并基础疾病MM患者的个体化持续治疗提供了真实世界实践参考。


特邀专家
浙江大学医学院附属第一医院血液科副主任,主任医师、博士生导师
浙江省医学会血液病学分会 常委
浙江医师协会血液病学分会常委
中华医学会血液病学分会感染学组 委员
中华医学会血液分会浆细胞疾病学组 委员
中华医师协会多发性骨髓瘤专委会 委员
从事血液病临床和基础讲究30年,擅长恶性血液病的诊治,特别是多发性骨髓瘤,淋巴瘤和难治急性白血病的治疗
获得国家科技进步二等奖2项
浙江省科技进步一等奖2项
主持国家自然科学基金一项
发表SCI论文40余篇
浙江大学医学院附属第二医院血液科 主任医师 博士
中国医师协会毕教委执委会评估工作委员会委员
中国肿瘤联盟浙江分会血液肿瘤专业委员
浙江省中西医结合学会血液学分会委员
浙江省医师协会MDS/MPN专业组委员
浙江省首届“百姓心目中-浙江有温度的好医生”称号
美国City of Hope 医学中心访问学者
主持参与国家自然科学基金3项、主持省厅、局级课题以及医学院教育改革项目多项,SCI期刊和国内核心期刊发表学术论文20余篇,参与编写并出版著作2部
获省科学技术进步奖三等奖一项,省医学科技二等奖一项,省教学成果二等奖一项
[1] Xiang Q, Lu M, Chu B, et al. Transition to IRD maintenance after DRD induction significantly deepens response in transplant-ineligible NDMM: A prospective multicenter study[J]. Blood, 2025,146(Supplement 1):4059.
[2] Moreau P, Masszi T, Grzasko N, et al. Oral Ixazomib, Lenalidomide, and Dexamethasone for Multiple Myeloma[J]. N Engl J Med, 2016,374(17):1621-1634.
[3] Vassilopoulos S, Vassilopoulos A, Kalligeros M, et al. Cumulative Incidence and Relative Risk of Infection in Patients With Multiple Myeloma Treated With Anti-CD38 Monoclonal Antibody-Based Regimens: A Systematic Review and Meta-analysis[J]. Open Forum Infect Dis, 2022,9(11):ofac574.
[4] Rifkin RM, Girnius SK, Noga SJ, et al. In-class transition (iCT) of proteasome inhibitor-based therapy: a community approach to multiple myeloma management[J]. Blood Cancer J, 2023,13(1):147.
[5] Leleu X, Lee HC, Zonder JA, et al. INSURE: a pooled analysis of ixazomib-lenalidomide-dexamethasone for relapsed/refractory myeloma in routine practice[J]. Future Oncol, 2024,20(14):935-950.
[6] Macro M, Hulin C, Vincent L, et al. Real-world effectiveness of ixazomib combined with lenalidomide and dexamethasone in relapsed/refractory multiple myeloma: the REMIX study[J]. Ann Hematol, 2023,102(8):2137-2151.
排版编辑:肿瘤资讯-李鑫






苏公网安备32059002004080号